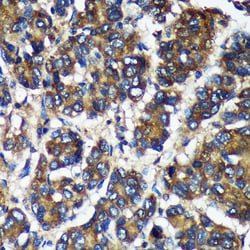
Invitrogen TMX2 Polyclonal Antibody 100 &mu;L | Buy Online | Invitrogen&trade; | Fisher Scientific
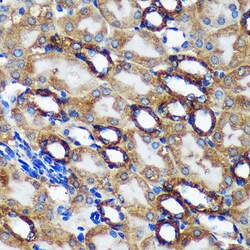
Invitrogen TMX2 Polyclonal Antibody 100 &mu;L | Buy Online | Invitrogen&trade; | Fisher Scientific

Learn More
Beschreibung
Positive Samples: U-251MG, HeLa, HepG2, A-549, Mouse liver, Mouse brain, Rat testis Immunogen sequence: KPPLYMGPEY IKYFNDKTID EELERDKRVT WIVEFFANWS NDCQSFAPIY ADLSLKYNCT GLNFGKVDVG RYTDVSTRYK VSTSPLTKQL PTLILFQGGK EAMRRPQIDK KGRAVSWTFS EENVIREFNL NELYQRAKKL SKAGDNIPEE QPVASTPTTV SDGENKKDK.

Spezifikation
Spezifikation
| Antigen | TMX2 |
| Anwendungen | ELISA, Immunohistochemistry (Paraffin), Western Blot, Immunocytochemistry |
| Klassifikation | Polyclonal |
| Konzentration | 1.67 mg/mL |
| Konjugat | Unconjugated |
| Zusammensetzung | PBS with 50% glycerol and 0.01% thimerosal; pH 7.3 |
| Gen | TMX2 |
| Gen-Zugriffsnummer | Q5XIK2, Q9D710, Q9Y320 |
| Gen-Alias | 2310042M24Rik; AA589631; Cell proliferation-inducing gene 26 protein; CGI-31; growth-inhibiting gene 11; My009; PDIA12; PIG26; protein disulfide isomerase family A, member 12; PSEC0045; thioredoxin domain containing 14; thioredoxin domain-containing protein 14; thioredoxin related transmembrane protein 2; thioredoxin-related transmembrane protein 2; thioredoxin-related transmembrane protein-like protein; TMX2; TXNDC14; Unknown (protein for MGC:134152); UNQ237/PRO270 |
| Gensymbole | TMX2 |
| Mehr anzeigen |
Indem Sie auf Absenden klicken, erklären Sie sich damit einverstanden, dass Fisher Scientific sich mit Ihnen in Verbindung setzen kann, um Ihr Feedback in diesem Formular zu bearbeiten. Wir werden Ihre Informationen nicht für andere Zwecke weitergeben. Alle bereitgestellten Kontaktinformationen werden in Übereinstimmung mit unserer Datenschutzrichtlinie aufbewahrt. Datenschutzrichtlinie.